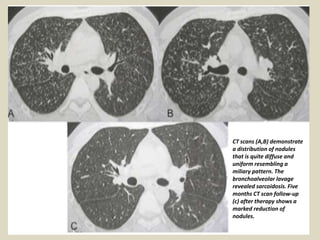
CT scans (A,B) demonstrate
a distribution of nodules
that is quite diffuse and
uniform resembling a
miliary pattern. The
bronchoalveolar lavage
revealed sarcoidosis. Five
months CT scan follow-up
(c) after therapy shows a
marked reduction of
nodules.

Sarcoidosis is an inflammatory disease characterized by non-caseating granulomas that can affect multiple organ systems. Pulmonary involvement occurs in up to 90% of patients and includes hilar and mediastinal lymphadenopathy in 95% of cases. On imaging, sarcoidosis demonstrates various patterns including micronodules with perilymphatic distribution, pulmonary masses/nodules, reticulation, ground glass opacities, and pleural effusion in rare cases. High-resolution CT is useful for evaluating the wide variety of radiological manifestations of pulmonary and extra-pulmonary sarcoidosis.

![Muscle-skeletal sarcoidosis The skeleton is affected in about 1-13% of patients
with generalized disease, complaining of bone and joint pain. Sarcoidosis usually
involves the phalanges of the hands and feet; conventional radiography, performed in
symptomatic patients, demonstrate either "lacy" osteolytic or osteosclerotic multiple
lesions, where the latter is less frequent. Large bones and axial skeleton involvement
is uncommon. In large bones, lesions usually demonstrate a lytic appearance with
indistinct or well-defined margins at conventional radiography. In the vertebrae, both
osteolytic lesions with sclerotic borders and diffuse osteosclerotic localizations are
possible [13, 19-20]. Lesions can be located in one or more contiguous or non-
contiguous vertebrae and they can also affect the pedicles. Patients may complain
of arthralgia in knees, ankles, elbows and wrists, but joint radiograms are usually
negative or demonstrate non-specific signs of osteoporosis and soft-tissue swelling.
These lesions usually demonstrate an uptake on bone scintigraphy, even before the
lesions are visible at conventional radiograms. The use of CT and MRI is rare and it is
usually performed to help differential diagnosis from other pathologies with skeletal
involvement, such as osseous metastases, lymphoma, myeloma and tuberculosis.
Sarcoidosis may also affect the muscles with myopathic or nodular type involvement.
On MR, sarcoid nodules show hypo-intense fibrotic central areas, with marginal
peripheral areas hyper-intense on T2-weighted images with enhancement after
gadolinium. These appearances may mimic a soft-tissue tumor. In the myopathic
type, the involved muscles demonstrate a high signal intensity on T2-weighted
images.](https://image.slidesharecdn.com/presentation1-1606070123261-230402154756-3670259a/85/presentation1-160607012326-1-pdf-99-320.jpg)



































